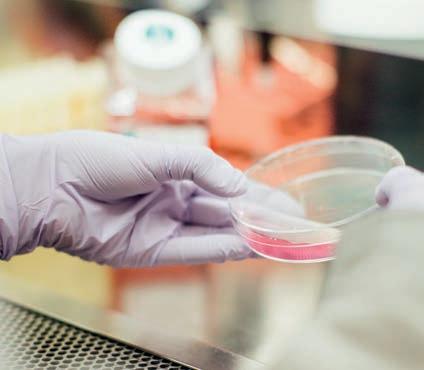

Complementos alimenticios:







Dr. Rath Health Programs
Postbus 657 | 6400 AR Heerlen | Países Bajos
Fax: 0031 - 457 111 119

info@rath-programs.com www.dr-rath.com
* L a Oficina de Patentes estadounidense ha reconocido determinadas combinaciones de micronutrientes desarrolladas en nuestro instituto de investigación. Es la primera vez que se confirma oficialmente la eficacia biológica de determinadas fórmulas de micronutrientes en los sistemas celulares del cuerpo humano. Para la concesión de las respectivas patentes, fue necesario demostrar la eficacia de cada ingrediente individual mediante un minucioso trabajo científico. El reconocimiento de nuestra investigación por parte de una agencia gubernamental estadounidense tiene implicaciones para todo el campo de la medicina natural basada en la ciencia.
BIENVENIDO A DR. RATH HEALTH PROGRAMS
DR. RATH FUNDADOR DE LA MEDICINA CELULAR
LA SALUD COMIENZA A NIVEL DE LAS CÉLULAS
NUESTRAS FÓRMULAS, NATURALMENTE PATENTADAS
EL SIGNIFICADO DE LA SINERGIA DE MICRONUTRIENTES
VITAMINA C, EL INGREDIENTE PRINCIPAL DE LAS FÓRMULAS DEL DR. RATH
ALIMENTOS: ¿UNA FUENTE ADECUADA DE NUTRIENTES CELULARES?
LAS TAREAS Y OBJETIVOS DE NUESTRO TRABAJO
NUESTRO PROYECTO DE HUERTOS ESCOLARES EN ÁFRICA
Este folleto le informa sobre el Programa de Nutrientes Celulares del Dr. Rath, que ofrece una variedad de fórmulas nutritivas innovadoras y orientadas a objetivos concretos, para la suplementación nutricional diaria. Nuestra empresa, Dr. Rath Health Programs, se diferencia de otras empresas de vitaminas en que es propiedad en su totalidad de una fundación sin ánimo de lucro. Con los beneficios generados, financiamos la investigación en tratamientos naturales con base científica y la difusión mundial de los resultados de estas investigaciones. Nuestros complementos alimenticios se desarrollan de acuerdo con los últimos descubrimientos científicos e incluso están patentados. Esto es único en el mundo.
Esperamos que las siguientes páginas le convenzan de la singularidad de nuestras fórmulas de complementos alimenticios. Al adquirir estos productos únicos, nos permite asesorarle y apoyarle en uno de los aspectos más importantes de su vida: su bienestar físico y su salud.
Le recomendamos consultar a un terapeuta o profesional sanitario para gestionar sus problemas de salud personal. Llámenos gratis si tiene alguna duda o necesita ayuda. Obtenga asesoramiento individual y sin compromiso sobre su objetivo personal de salud: no le costará nada, salvo un poco de tiempo.
Estaremos encantados de atenderlos entre las 8.30 y las 17.00 horas de Lunes a Viernes.

Nuestro teléfono gratuito es: 900 – 83 10 24* Esperamos su llamada.
Con nuestros mejores deseos para su salud,
Dr. Rath Health Programs B.V. es una de las pocas empresas especializadas en la investigación sobre los micronutrientes y el desarrollo de suplementos nutricionales que lleva el nombre de un científico. Y por una muy buena razón el Dr. Rath descubrió que las decisiones sobre la salud y la enfermedad se toman a nivel de las células. Enfermedades comunes como los infartos de miocardio, el derrame cerebral y el cáncer son consecuencia de una deficiencia crónica de vitaminas, minerales, aminoácidos y otros micronutrientes -también conocidos como nutrientes celulares- en millones de células del organismo. Si se suministran suficientes micronutrientes a las células, se pueden evitar las enfermedades. El Dr. Rath acuñó la expresión “medicina celular” para describir este descubrimiento. El Dr. Rath fue colega y amigo personal del Dr. Linus Pauling, dos veces ganador del premio Nobel. Juntos, estos dos científicos publicaron varios trabajos de investigación pioneros, sobre el papel de los micronutrientes en la prevención de los trastornos cardiovasculares. Tras la muerte de Pauling en 1994, el Dr. Rath y su equipo de científicos del Instituto de Investigación -fundado por él- continuaron sistemáticamente desarrollando la investigación sobre las vitaminas. Los descubrimientos pioneros del Dr. Rath en el ámbito de la salud natural sentaron al mismo tiempo las bases de las innovadoras combinaciones de sustancias naturales, como las que aparecen disponibles en el Programa de Nutrientes Celulares del Dr. Rath.

Si sabe cómo funciona su cuerpo, también sabrá por qué a veces se siente en forma y a veces apático, pero también cuando está sano existe la posibilidad de que se pueda enfermar.
Su salud depende de la unidad más pequeña de su cuerpo: la célula. Veámosla más de cerca.
• Nuestro cuerpo está formado por miles de millones de células, las unidades vivas más pequeñas de nuestro organismo. Su buen funcionamiento refleja el vigor que tenemos los seres humanos.
• Si una célula no funciona, el órgano -y por consiguiente el cuerpo- no puede funcionar correctamente. En estos casos, por decirlo de forma sencilla, la célula tiene hambre: le faltan nutrientes.
• La capacidad de rendimiento y la enfermedad se deciden a nivel celular: si la célula sufre carencias, deja de funcionar parcial o totalmente, enferma y/o muere.
Lo que todas las células tienen en común es que deben recibir nutrientes para cumplir sus funciones de forma óptima. Por lo tanto, nuestra nutrición
tiene una importancia fundamental para la vitalidad y el bienestar. Además del oxígeno, el agua y los llamados “macronutrientes” -proteínas, hidratos de carbono y grasas-, son sobre todo los nutrientes celulares los que impulsan los procesos celulares que son importantes para la vida.
La mayoría de los nutrientes celulares son responsables de acelerar miles de reacciones bioquímicas en el metabolismo de cada célula o, de hecho, de hacerlas posibles en primer lugar. La estructura, la protección, el suministro de energía y el funcionamiento de nuestras células y órganos -y, en definitiva, de nuestro cuerpo- están directamente relacionados con los nutrientes celulares.
La salud se decide a nivel celular
Células musculares
Células barrera (endotelio)
eritrocitos plaquetas linfocitos
Células sanguíneas
Neuronas
Células hepáticas
Célula del tejido conjuntivo
Una dieta sana y equilibrada con una amplia selección de frutas y vegetales frescos y ecológicos, constituye la base para aportar nutrientes a nuestro organismo. Nuestras fórmulas complementan esta selección de nutrientes con importantes vitaminas, minerales, oligoelementos y una serie de otros ingredientes que favorecen la salud. Apoyan el metabolismo en general y suponen una valiosa contribución al cuidado básico de la salud a cualquier edad.
Al decidirse en comprar nuestra gama de micronutrientes, ha hecho una buena elección. Está comprando productos que se distinguen de la mayoría de los suplementos nutricionales del mercado, ya que han sido desarrollados sobre la base de la investigación científica y su eficacia ha sido probada.


Fórmula sinérgica para la suplementación nutricional diaria. En nuestra tienda online www.dr-rath.com puede conseguir este y muchos otros productos. – Fácil de acceder a través del código QR.

Un requisito fundamental para poder ofrecerle productos de la más alta calidad con beneficios probados es nuestra estrecha colaboración con el Instituto de Investigación del Dr. Rath, un centro internacional líder en el ámbito de la salud natural basada en la ciencia.
La mayoría de las empresas del sector de los suplementos nutricionales no llevan a cabo ningún estudio científico o clínico propio. De hecho, se basan en publicaciones de terceros (incluida la nuestra) para aportar pruebas de la supuesta eficacia de sus productos.
Escanee el código QR y lea los estudios en el siguiente enlace: www.drrathresearch.org

La Dra. A. Niedzwiecki, directora del Instituto de Investigación del Dr. Rath desde hace más de 20 años, y una de las líderes a nivel internacional en el campo de la investigación científica sobre micronutrientes.

El Instituto de Investigación del Dr. Rath, está considerado como pionero en el ámbito de la investigación de la salud natural con base científica, ya que fuimos los primeros en someter nuestra gama de suplementos nutricionales a una investigación en profundidad a nivel celular y de todo el organismo. Los resultados de nuestra propia investigación – llevada a cabo por el equipo del Dr. Rath y la Dra. Niedzwiecki durante más de 10 años – se han publicado en numerosas revistas científicas independientes.

Durante más de una década, nuestros científicos han investigado la eficacia, la seguridad y los beneficios de las sinergias de micronutrientes en el control natural de varios procesos de enfermedad. Nuestro objetivo es hacer que los remedios naturales basados en la ciencia formen una parte importante de un sistema de salud orientado al paciente en todos los países del mundo.

Como nuestra empresa de vitaminas y el Instituto de Investigación del Dr. Rath pertenecen a una fundación benéfica, usted no sólo está apoyando su salud al comprar nuestros productos. También está contribuyendo a la continuación de nuestro compromiso de tres décadas con las terapias naturales y la salud humana.

La Oficina de Patentes y Marcas de EE.UU., un organismo gubernamental estadounidense, ha reconocido oficialmente la eficacia de nuestras combinaciones de micronutrientes desarrolladas científicamente. Hasta la fecha, somos la primera y única organización del mundo que patenta sistemáticamente sus avances en la investigación de micronutrientes, garantizando así que se asientan sobre una base científicamente probada. Las implicaciones
de esta estrategia son de gran alcance: en todo el mundo, por primera vez, se pueden prevenir problemas de salud comunes y graves de forma natural, segura y eficaz. A largo plazo, esto reducirá las enfermedades comunes a una fracción de su incidencia actual.
NUESTRAS FÓRMULAS
PATENTADAS:
Relavit™

Tecnología patentada para la relajación natural de la pared de los vasos sanguíneos
Artículo nº 0005
Diacor™

Tecnología patentada para la reducción natural del azúcar en sangre y la estimulación de la producción de insulina
Artículo nº 0007





YouCell™-V Tecnología patentada para la inhibición natural de las vías de infección por coronavirus


Artículo nº 048
EpiQuercican™

Lensivit™ Tecnología patentada para proteger de forma natural la función ocular frente al daño oxidativo.

Artículo nº 047
Tecnología patentada para la inhibición natural de la proliferación de células cancerosas
Artículo nº 019
Los efectos biológicos de las combinaciones de micronutrientes que hemos investigado y probado se han patentado en los ámbitos de la hipertensión, la diabetes, las infecciones víricas, el cáncer y la salud ocular.

Para cada una de estas patentes ha habido que documentar un gran número de estudios científicos que demostraran tanto la composición específica de vitaminas y otros micronutrientes como la eficacia biológica de estas combinaciones.
• Relajación natural de la pared de los vasos sanguíneos
• Reducción natural del azúcar en sangre y estimulación de la producción de insulina
• Inhibición natural de las vías de infección por coronavirus

• Inhibición natural de la proliferación de células cancerosas
• Protección natural de la función ocular frente al daño oxidativo
Las vitaminas, los minerales, los aminoácidos y otros micronutrientes nunca aparecen en la naturaleza por sí solos o aislados. Están conectados entre sí en las células de nuestro cuerpo como una red, y la eficacia óptima de un micronutriente individual en esta red depende de la presencia de otros micronutrientes y componentes nutricionales. Sólo en combinación pueden estas sustancias alcanzar su plena eficacia.

Los efectos mutuamente beneficiosos que tienen las sustancias entre sí, no sólo potencian sus propios beneficios. También hacen posible que otros nutrientes sean mejor absorbidos y utilizados por los procesos metabólicos.
Aplicando el principio de la sinergia, podemos conseguir este efecto máximo con nuestras fórmulas de micronutrientes sin recurrir a mega dosis de un solo nutriente.
¿Quiere recibir más información? Solicite nuestro folleto gratuito “Productos únicos para la Salud” (Nº de artículo 63041).
La vitamina C es probablemente la más conocida de todas las vitaminas, y con razón: casi ninguna otra vitamina cumple tantas funciones diferentes en el organismo. Una forma importante de vitamina C , es la vitamina C tamponada, que se forma cuando el ácido ascórbico se combina con un mineral (normalmente calcio, magnesio o potasio) y neutralizan el efecto acidificante del ácido ascórbico, lo cual la hace más suave para el estómago, evitando así molestias estomacales para algunas personas sensibles. La vitamina C tamponada también se absorbe mejor en el organismo.
El palmitato de ascorbilo es una forma especialmente eficaz de vitamina C. Sin embargo, debido a su elevado coste, rara vez se utiliza en los suplementos nutricionales. El palmitato de ascorbilo es liposoluble, por lo que puede integrarse en las membranas celulares y otras estructuras celulares ricas en lípidos, y proteger estas estructuras contra la oxidación.

La composición – basada en evidencias científicas –de las fórmulas del Dr. Rath es lo que hace que nuestro programa de suplementos nutricionales sea distintivo. La alta calidad de nuestros productos demuestra el compromiso que sentimos con su salud.
Nuestros productos:
• están libre de sustancias vegetales genéticamente modificadas
• no contienen aromas ni colorantes artificiales
• no contienen gelatina (en su lugar utilizamos, por ejemplo, hipromelosa derivada de fibras celulares vegetales)
• no contienen levadura ni glutamato monosódico
• libres de ácidos grasos trans
• libres de alérgenos como el gluten*, la lactosa y el trigo
* Excepción: la fórmula de fibra dietética Dr. Rath’s Phytobiologicals™ Balance Control
Ingredientes de origen natural: siempre que es posible, utilizamos ingredientes y aditivos de origen natural como:
• Frutas, en particular cítricos, papaya, piña, semillas de uva, cocos
• O tras plantas, en particular el maíz, la soja, la remolacha azucarera, el té verde, las algas, las caléndulas, los extractos de corteza de pino
• Condroitina y glucosamina (en Arteriforte™) derivadas del cartílago natural

En los ingredientes se hace una distinción entre los ingredientes activos y lo que se conoce como aditivos.
Nuestras fórmulas de sustancias vitales celulares constan de muchos componentes individuales diferentes que actúan conjuntamente para ayudar a optimizar las funciones celulares naturales. Cada sustancia individual contribuye al efecto y la combinación se ajusta científicamente de forma individual para cada producto. Las vitaminas, los aminoácidos, los minerales, los extractos de plantas („fitobiológicos“) y otras sustancias vitales para las células se indican en la etiqueta con la cantidad respectiva de una dosis diaria.

Sin embargo, „activo“ también significa que utilizamos formas de alta calidad de sustancias vitales celulares que se caracterizan por una absorción especialmente buena y una metabolización rápida. Esto distingue nuestras fórmulas de alta calidad de los productos baratos de imitación.
Para hacer posible una absorción más rápida y, por lo tanto, proporcionar una biodisponibilidad óptima de los nu -
trientes celulares en el cuerpo, nuestros minerales y oligoelementos están unidos orgánicamente a los aminoácidos glicina o metionina. De esta manera, podemos evitar que los nutrientes celulares individuales se contrarresten entre sí.
Un aditivo es una sustancia auxiliar que es importante para la producción de la cápsula, pero que no contribuye directamente a su efecto. Un buen ejemplo de ello es el sabor a limón de la cápsula de Vitacor Plus, que procede de una fuente natural de origen vegetal. Ponemos especial cuidado en evitar por completo los aditivos innecesarios o cuestionables.
CONSUMO
Las fórmulas de nutrientes celulares deben ingerirse repartidas a lo largo del día durante las comidas con abundante líquido (agua, zumo, té). Así se garantiza una concentración constante en el torrente sanguíneo y una absorción uniforme de los nutrientes por parte del organismo, así como una mejor absorción de las vitaminas liposolubles E, D y betacaroteno.


Si toma varias fórmulas al día, puede ingerir los comprimidos también a la hora de la merienda.
DURACIÓN DEL CONSUMO para el cuidado básico de la salud de nuestro cuerpo – por ejemplo en forma de la combinación básica Vitacor Plus™ & Dr. Rath’s Phytobiologicals™ –debe ser un hábito regular y a largo plazo. A lo largo de nuestra vida, millones de células consumen la energía celular que necesitamos para abastecer a nuestro cuerpo.
Para más información , consulte nuestro catálogo de productos gratuito “Programa de micronutrientes celulares vitales” del Dr. Rath” (Nº de artículo 20991).

Los alimentos naturales, como las frutas y los vegetales, crecen principalmente en monocultivos, es decir, todo un campo está cubierto por un solo tipo de planta. Esto hace que el rendimiento sea mayor y da al agricultor la oportunidad de obtener beneficios con sus productos.
Pero la consecuencia de los monocultivos es que el suelo se agota unilateralmente debido a las necesidades específicas de nutrientes de la planta, y hay que utilizar fertilizantes para provocar el crecimiento de la misma. Esto es contrario a la regeneración natural del suelo, y la planta que crece en él está ahora agotada de nutrientes vitales y posiblemente será incapaz de crear la inmunidad para protegerse de los depredadores y otras influencias. En consecuencia, hay que utilizar productos fitosanitarios.
Además, el consumo de frutas y vegetales frescos ha disminuido constantemente en los últimos años. Tanto la disminución del contenido de nutrientes como la reducción del consumo de productos naturales contribuyen cada vez más a que no obtengamos
suficientes nutrientes celulares de nuestros alimentos. Si el consumo de nutrientes celulares a través de los alimentos es insuficiente, los suplementos nutricionales pueden suplir estas carencias y, por tanto, contribuir a prevenir las deficiencias.
Reducción del contenido de micronutrientes en las zanahorias y las judías
Pérdidas 1985-2002
Trabajamos bajo el auspicio de una fundación: la Dr. Rath Health Foundation. Esto significa que todos los beneficios obtenidos se reinvierten en nuevas investigaciones vitales y en la correspondiente labor de educación sanitaria. La base de nuestro trabajo es la investigación de los nutrientes celulares y su significado para la salud. La divulgación de estos conocimientos debería allanar el camino hacia una nueva forma de asistencia sanitaria basada en remedios naturales eficaces, económicos y sin efectos secundarios.
El objetivo general de nuestro trabajo es una estrategia sobre salud orientada a la prevención. Un sistema inmunitario fuerte es sólo un ejemplo de un área en la que ofrecemos soluciones naturales y eficaces. Restablecer y mantener la salud de millones de personas en todo el mundo es nuestra prioridad. ¡Naturalmente!
Resumen de nuestros objetivos:
• Educación sanitaria
• Promoción de remedios naturales con base científica
• Investigación y desarrollo continuo de suplementos nutricionales
• L a creación de un sistema de salud moderno basado en la prevención


El cambio hacia una asistencia sanitaria preventiva no puede limitarse a unos pocos países ricos e industrializados.
Como parte del “Movimiento de la Vida” se crearon proyectos de huertos escolares, donde los niños y jóvenes aprenden los beneficios para la salud de las frutas y verduras cultivadas en casa. Planifican y cuidan los huertos escolares, fomentan la jardinería comunitaria en los pueblos donde viven sus familias y contribuyen a mejorar la salud de regiones enteras.

El éxito de nuestra iniciativa de huertos se puede cuantificar en cifras: en Uganda, África Oriental, uno de los países más pobres del mundo, se han plantado más de 12.000 árboles frutales desde que comenzó el proyecto en el 2015. Más de 100.000 personas en Uganda se han beneficiado directamente del proyecto desde entonces (a partir de julio de 2020).
Al comprar cualquiera de nuestros productos, también estarás apoyando el proyecto “Movimiento de la Vida” del Dr. Rath Health Foundation en África, y ayudando a mejorar vidas.
Salud para todos significa educación para todos.
Puede encontrar más información sobre este y otros proyectos del “Movimiento de la Vida” en www.movement-of-life.org. Basta con escanear este código QR.

© Dr. Rath Health Programs B.V.

Ahora ha obtenido una primera visión de nuestro grupo de empresas y ha aprendido lo que hace que las Fórmulas de Vitalidad Celular del Dr. Rath sean tan especiales y valiosas. Ha leído sobre los científicos que están detrás de la investigación de los micronutrientes y la formulación de los productos, ha aprendido sobre la importancia de las sinergias de los micronutrientes y su efecto positivo en las células del cuerpo. Ha podido comprobar por sí mismo los elevados niveles de exigencia que establecemos para la calidad de nuestros productos únicos. Se ha hecho una idea del trabajo de nuestra fundación y de nuestro gran objetivo “Salud para todos” basándose en el ejemplo de un proyecto del Movimiento de la Vida.
Una vez que haya tomado los nutrientes celulares durante un tiempo y se haya convencido de su valor para su bienestar, le recomendamos encarecidamente que pruebe nuestra suscripción de nutrientes celulares.
Elija su fórmula preferida y déjenos hacer el resto. Le entregaremos automáticamente los productos de su elección cada dos meses. No hay gastos de envío y recibirá dos meses de suministro cada vez, por lo que nunca se quedará sin su fórmula favorita. Y por si esto no fuera suficiente incentivo para optar por la suscripción: sus fórmulas del 12º mes serán un regalo nuestro*.
Las ventajas de la suscripción:

• Productos gratuitos en el 12º mes
• Ya no tendrá que pagar gastos de envío
• Sin costes adicionales
• No volver a olvidar el pedido
* Con entregas de intervalos de dos meses, la sexta entrega cuesta a los suscriptores solo la mitad del precio. Por lo tanto, obtendrá un mes gratis (siempre que no haya cambios en la suscripción dentro del año actual). Tenga en cuenta: para fi nalizar la suscripción, debe cancelar al menos 14 días antes de la fecha de entrega prevista. La renovación de la suscripción es posible solo tres meses después de la cancelación.


Ahora que es un fan de nuestros productos de alta calidad científicamente probados, ¿le gustaría compartir sus beneficios con sus amigos y familiares? Puede hacerlo fácilmente a través de nuestro Programa de Colaboración con la Alianza del Dr. Rath. Será recompensado por su compromiso, y no tendrá ninguna obligación de hacer pedidos para usted, comprar en stock o alcanzar un mínimo de ventas. Sólo tiene que registrarse y empezar a compartir los conocimientos adquiridos o informar de sus experiencias con nuestros productos de salud.

En nuestra página web encontrará un vídeo explicativo y más información, por ejemplo, sobre nuestra oferta educativa. El enlace a la misma es a través del siguiente código QR:

Simplemente llámenos si tiene más preguntas. Puede ponerse en contacto con nuestro equipo de asesores entre las 8.30 y las 17.00 horas de Lunes a Viernes.

Nuestro teléfono gratuito es: 900 – 83 10 24*
Esperamos haber despertado su interés por nuestro Programa de Nutrientes Celulares, por nuestro trabajo y que esté satisfecho con nuestros productos.
Con nuestros mejores deseos, Su equipo del Dr. Rath
Dr. Rath Health Programs B.V.

Postbus 657 | 6400 AR Heerlen | Países Bajos
Fax: 0031 - 457 111 119
info@rath-programs.com www.dr-rath.com
